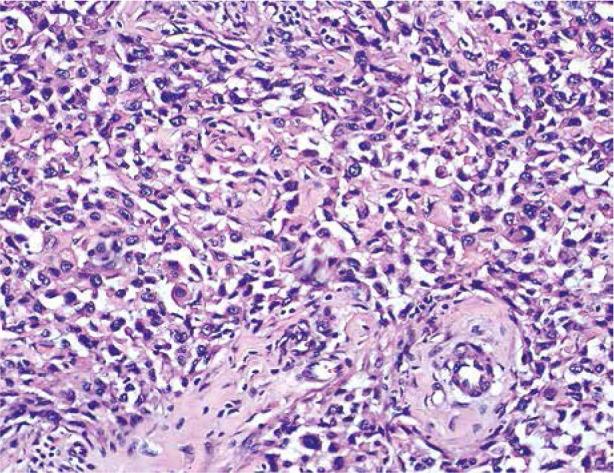

外阴平滑肌肉瘤:一例报告
Leiomyosarcoma of the vulva: a case report.
作者信息
Yordanov Angel, Slavchev Stanislav, Kostov Stoyan, Strashilov Strahil, Ivanov Ivan, Nikolova Margarita
机构信息
Department of Gynaecological Oncology, Medical University of Pleven, Bulgaria.
Department of Gynecology, Medical University of Varna, Bulgaria.
出版信息
Prz Menopauzalny. 2020 Dec;19(4):184-187. doi: 10.5114/pm.2020.101949. Epub 2021 Jan 7.
INTRODUCTION
Leiomyosarcoma of the vulva is a rare disease accounting for about 1% of all primary vulvar neoplasia but it is the most common type of vulvar sarcomas. Usually it arises from the smooth muscles, blood vessels, rough ligaments, and erector-pili muscles. No treatment algorithms have been established yet. Tumour excision with clean resection lines is considered sufficient, with radiation therapy applied in certain cases.
CASE REPORT
We report a case of a 73-year old patient in whom the disease was manifested by pain syndrome and rapidly growing mass with irregular margins in the symphysis area and satellite nodules. She underwent extensive local excision followed by radiation therapy.
DISCUSSION
Isolated cases and limited series of LMS cases have been described in literature. Leiomyosarcoma is most commonly localized to the labia majora, the Bartholin gland area, clitoris and labia minora. It most often affected perimenopausal women but in younger and pregnant patients was described. The diagnosis is not always easy and different histological markers has to be used. There are no definitive therapeutic algorithms due to the rarity of the disease. The management is surgical treatment and the entire tumour must be removed with histologically verified clean resection margins, followed by radiation therapy in some cases.
CONCLUSIONS
Vulvar tumours are difficult to distinguish macroscopically. Accurate histological diagnosis allows adequate treatment.
引言
外阴平滑肌肉瘤是一种罕见疾病,约占所有原发性外阴肿瘤的1%,但它是外阴肉瘤最常见的类型。通常它起源于平滑肌、血管、粗韧带和竖毛肌。目前尚未建立治疗方案。肿瘤切除且切缘干净被认为足够,某些情况下需进行放射治疗。
病例报告
我们报告一例73岁患者,该疾病表现为疼痛综合征,耻骨联合区域有边缘不规则且迅速生长的肿块及卫星结节。她接受了广泛局部切除,随后进行放射治疗。
讨论
文献中描述了孤立病例及有限系列的平滑肌肉瘤病例。平滑肌肉瘤最常位于大阴唇、巴氏腺区域、阴蒂和小阴唇。它最常影响围绝经期女性,但也有在年轻和怀孕患者中的报道。诊断并不总是容易,必须使用不同的组织学标志物。由于该疾病罕见,没有明确的治疗方案。治疗方法是手术治疗,必须切除整个肿瘤,切缘经组织学证实干净,某些情况下随后进行放射治疗。
结论
外阴肿瘤在宏观上难以区分。准确的组织学诊断有助于进行充分治疗。